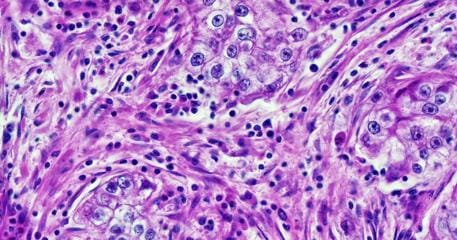

- SkynetAndChill by druce.ai
- Posts
- AI Reading for Sunday December 21
AI Reading for Sunday December 21
crouching tiger, hidden 3rd-party benchmarks
Republicans on House Foreign Affairs Committee seek oversight over deals to send chips to China, others. - GlobalSecurity.org
hey don’t hog all the pay-to-play
Sora Wars: The Mouse Awakens

field promotion to major algorithm
bend it like Bengio
congrats, you’re being interviewed and ghosted by an algorithm
tax bots, train humans

Karpathy Wrapped: year in review - karpathy
my wrapped: scrolled a lot, accomplished nothing

the Emmy for worst remix goes to…
on the Internet everyone knows you’re a dog now, and what your farts smell like
AI models compete for your affection: Inside the race to build the world’s best friend - The New York Times
disrupting human relationships and emotional well-being as a service
more on task than a PhD student popping handfuls of Ritalin
hard for e.g. Amazon to block agents when they control your own Chrome. also beware of agents running amok. don’t exfiltrate my browser history anywhere
Cursor buys AI code-review startup Graphite - TechCrunch
Tesla scales its robotaxi test, recruits safety drivers from its assembly line to the taxi line. - Business Insider
After SF blackout impacts traffic lights, Waymos make it much worse by stopping in the middle of intersections. - Mission Local
I'll believe when I see robots demo-ing e.g. vacuums in controlled sales floor environments. Great for selling since humans are programmed to be attentive to human-like objects.
2 legs, 0 PMF.
Walking on 2 feet is a useless skill in practice.
In indoor environments, wheeled or static robots with working hands would be actually useful. In unimproved outdoor environments, 4 legs maybe better.

Gary Marcus: Six (or seven) predictions for AI 2026 from a Generative AI ‘realist’ - The Potential Surface
just because a lot of people are crazy, it doesn’t make you a psychiatrist, and just because there’s a lot of crazy hype, it doesn’t make you a realist
Follow the latest AI headlines via SkynetAndChill.com on Bluesky